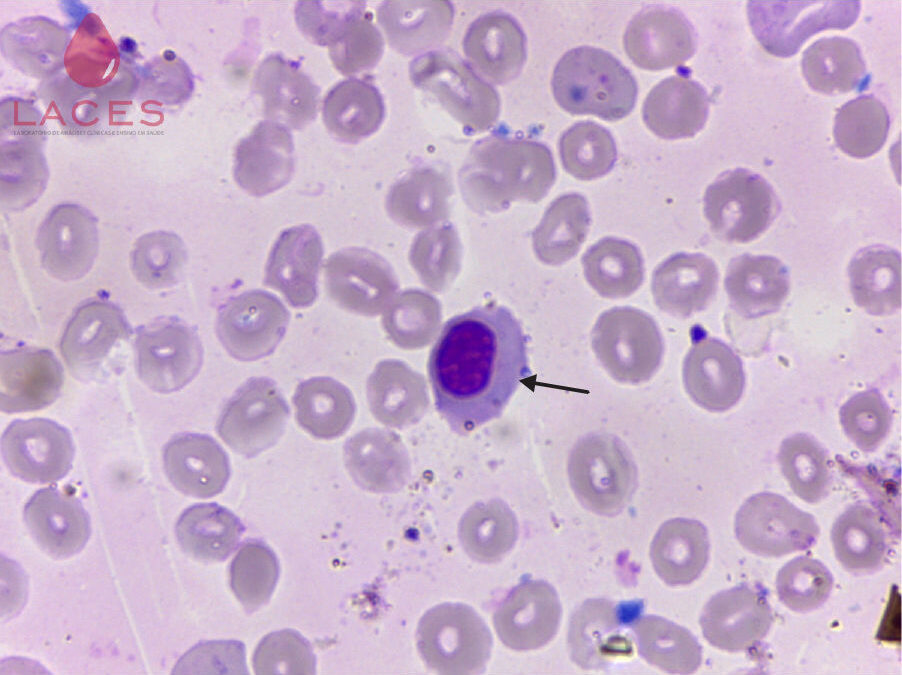
Novo episódio do videocast gratuito da Sysmex aborda o sinal de alerta para eritroblastos circulantes

“Sinal de alerta: eritroblastos circulantes” é o tema do mais novo episódio da série de videocasts da Sysmex, referência mundial em hematologia, e associado à CBDL.
A série é voltada para profissionais da saúde que buscam aprimorar os seus conhecimentos e se manter atualizados com as últimas descobertas e tendências no campo da hematologia. Para este terceiro episódio, os profissionais convidados foram o especialista e professor de hematologia Marcos Kneip Fleury e a especialista e consultora em hematologia Maria Silva Martinho.
Para assistir, basta se inscrever gratuitamente no portal sysmex-latam.com/caresphere.
Episódios sobre reticulócitos e plaquetas
O segundo episódio da série abordou o tema: “A importância da contagem de reticulócitos no diagnóstico inicial e diferencial das anemias”. Participaram o médico hematologista do Hospital Nove de Julho e do Hospital Sírio-Libanês, Paulo Silveira, e a professora e chefe de hematologia do Hospital das Clínicas de Botucatu – FMB – Unesp, Lígia Niéro de Melo.
Já o primeiro episódio, que marcou a estreia do videocast em maio, teve como assunto o “Papel das plaquetas na inflamação e nas doenças cardiovasculares”.
Os convidados foram o médico hematologista do Hospital Israelita Albert Einstein e do Hospital das Clínicas da Faculdade de Medicina da Universidade de São Paulo, Afonso Celso Almeida Cardoso, e a professora e coordenadora do Curso de Especialização em Hematologia Laboratorial da PUCRS, Terezinha Paz Munhoz. (Com informações da KB!COM – 04.08.23)